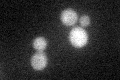
YPL171C
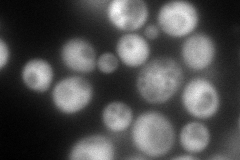
YPL171C
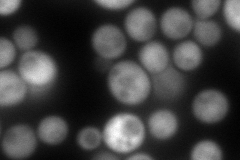
YPL171C
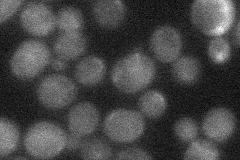
YPL171C
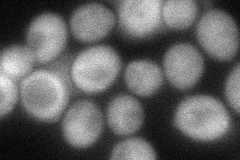
YPL171C
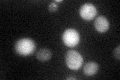
YPL171C

View description
Conserved NADPH oxidoreductase containing flavin mononucleotide (FMN), homologous to Oye2p with slight differences in ligand binding and catalytic properties; expression induced in cells treated with the mycotoxin patulin
Localization:
Intensity:
Fold change:
Significance:
-
C’ GFP library in SD
cytosol23.8 -
N' NOP1pr-GFP in SD
cytosol232.407 -
N' TEF2pr-mCherry in SD
cytosol251.033 -
N' NATIVEpr-GFP in SD
below threshold24.5523 -
N' TEF2pr-VC and Cyto-VN in SD
cytosol67.0226 -
C’ GFP library in SD+DTT

cytosol23.780.99No -
C’ GFP library in SD+H2O2

cytosol41.291.73Yes -
C’ GFP library in Starvation Media
cytosol80.943.4Yes -
C’ GFP library on the background of Pup2-DaMP

N/A -
C’ GFP library on the background of CCT mutant

N/A0N/AYes
